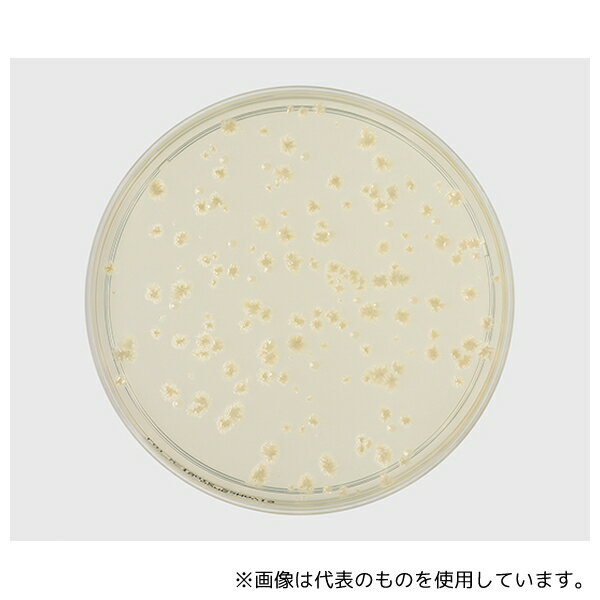
ベクトン・ディッキンソン 252967 BD BBL(TM) コロンビア寒天培地 1個(5枚×5パック入)

「花・ガーデン・DIY > DIY・工具」の商品をご紹介します。

【AS ONE】分析・特殊機器|分析機器その他ベクトン・ディッキンソン 212087 BD BBL(TM) DHL寒天培地 20枚
【アズワン AS ONE】分析・特殊機器 分離・分析ロシ 分析機器その他 ●DHL寒天培地は、病原性腸内細菌の選択分離用の培地で、特にSalmonella、Shigella、Y. enterocoliticaなどの分離を目的とします 商品の仕様 ●生培地 ●用途:腸内細菌用 ●入数:20枚入 ●JANコード:382902120872 【※ご注意ください】商品は代表の画像を使用しています。
4895 円 (税込 / 送料込)

島津ダイアグノスティクス SSB寒天培地(顆粒)300g 05025 1個(300g入)
島津ダイアグノスティクス SSB寒天培地(顆粒)300g 05025 1個(300g入)●本培地は、Salmonellaと赤痢菌(Shigella)の選択分離培地である。●糞便検体の分離培養に用いる。●大腸菌、雑菌の発育抑制はSS寒天培地よりもやや弱いが、SS寒天培地上では発育困難なSalmonella(S.pullorum, S.enteritidisなど)もよく発育する。●包装:300g●貯蔵方法:室温に保存(要防湿)●サイズ:W9cm×H20cm×D9cm
11927 円 (税込 / 送料別)

【AS ONE】分析・特殊機器|分析機器その他ベクトン・ディッキンソン 251361 BD BBL(TM) CHROMagar(TM) O157寒天培地 20枚
【アズワン AS ONE】分析・特殊機器 分離・分析ロシ 分析機器その他 ●BD CHROMagar(TM) O157寒天培地は、臨床材料・保菌者検査材料および食品検査材料などからE. coli O157:H7を検出するための新しい選択分離培地です 商品の仕様 ●生培地 ●用途:O157用 ●入数:20枚入 ●JANコード:382902513612 【※ご注意ください】商品は代表の画像を使用しています。 【※ご注意ください】0
7370 円 (税込 / 送料別)

【AS ONE】分析・特殊機器|分析機器その他ベクトン・ディッキンソン 224200 BD Difco(TM) 麦芽寒天培地
【アズワン AS ONE】分析・特殊機器 分離・分析ロシ 分析機器その他 ●酵母および真菌の検出と分離用です。 商品の仕様 ●粉末培地 ●用途:酵母・真菌用 ●質量:500g ●JANコード:382902242000 【※ご注意ください】商品は代表の画像を使用しています。
24200 円 (税込 / 送料込)

【AS ONE】分析・特殊機器|分析機器その他ベクトン・ディッキンソン 251138 BD BBL(TM) BYチョコレート寒天培地 20枚
【アズワン AS ONE】分析・特殊機器 分離・分析ロシ 分析機器その他 ●BYチョコレート寒天培地は臨床材料からHaemophilus、 Neisseriaなどの栄養要求の厳しい細菌の分離培養に用いられます 商品の仕様 ●生培地 ●用途:一般細菌用 ●入数:20枚入 ●JANコード:382902511380 【※ご注意ください】商品は代表の画像を使用しています。
7117 円 (税込 / 送料込)

栄研化学 パールコアR SS寒天培地(240g) E-MA81 1個
栄研化学 パールコアR SS寒天培地(240g) E-MA81 1個●硫化水素産生性と糖分解能によるサルモネラ及びシゲラの選択分離用(大腸菌発育阻止作用が強く多量の糞便塗抹ができる)●顆粒●内容量:240g
9619 円 (税込 / 送料別)

島津ダイアグノスティクス アキュディア? SSB寒天培地 顆粒 20L 05024 1個(20L入)
島津ダイアグノスティクス アキュディア? SSB寒天培地 顆粒 20L 05024 1個(20L入)●本培地は、Salmonellaと赤痢菌(Shigella)の選択分離培地である。●糞便検体の分離培養に用いる。●大腸菌、雑菌の発育抑制はSS寒天培地よりもやや弱いが、SS寒天培地上では発育困難なSalmonella(S.pullorum, S.enteritidisなど)もよく発育する。●包装:20L(60g×20)●貯蔵方法:室温に保存(要防湿)●サイズ:W24cm×H15cm×D19cm
42451 円 (税込 / 送料別)

【AS ONE】分析・特殊機器|分析機器その他ベクトン・ディッキンソン 211124 BD BBL(TM) コロンビア寒天基礎培地
【アズワン AS ONE】分析・特殊機器 分離・分析ロシ 分析機器その他 ●臨床および非臨床の各種の検体から栄養要求の厳しい細菌並びに一般の細菌の分離、培養を目的とした高栄養の汎用培地の作製に使用します。 商品の仕様 ●粉末培地 ●局方対応 ●用途:一般細菌用 ●質量:500g ●JANコード:382902111245 【※ご注意ください】商品は代表の画像を使用しています。 【※ご注意ください】0
17094 円 (税込 / 送料別)

【AS ONE】分析・特殊機器|分析機器その他ベクトン・ディッキンソン 251953 BD BBL(TM) CLED寒天培地 20枚
【アズワン AS ONE】分析・特殊機器 分離・分析ロシ 分析機器その他 ●CLED寒天培地は、尿中細菌の定量と分離培養に適しており、尿路感染症を診断するのに推奨されます 商品の仕様 ●生培地 ●用途:尿中細菌用 ●入数:20枚入 ●JANコード:382902519539 【※ご注意ください】商品は代表の画像を使用しています。 【※ご注意ください】0
6600 円 (税込 / 送料別)

栄研化学 粉末培地(分包顆粒) パールコアR ポテトデキストロース寒天培地 20袋入 E-KF11 1箱(20袋入)
栄研化学 粉末培地(分包顆粒) パールコアR ポテトデキストロース寒天培地 20袋入 E-KF11 1箱(20袋入)●真菌の増殖・分離・菌数測定用●顆粒●内容量:1L分×20袋
17416 円 (税込 / 送料別)

【送料無料】日水製薬 アキュディア? R2A寒天培地(顆粒)「ニッスイ」 300g 05515 1本
メーカー 日水製薬 商品カテゴリ 実験用器具・消耗品>実験用消耗品 発送目安 1日~2日以内に発送予定(土日祝除) お支払方法 銀行振込・クレジットカード 送料 送料無料 特記事項 その他 [島津ダイアグノスティクス]
9375 円 (税込 / 送料込)

【AS ONE】分析・特殊機器|分析機器その他栄研化学 E-MR93 ポアメディア?羊血液寒天培地M58 10枚入
【アズワン AS ONE】分析・特殊機器 分離・分析ロシ 分析機器その他 ●一般細菌及び栄養要求の厳しい菌検査用 5%羊血液添加(特にA群溶血レンサ球菌のβ溶血環が鮮明) 商品の仕様 ●生培地 ●内容量:10枚 ●JANコード:4987026156200 【※ご注意ください】商品は代表の画像を使用しています。 【※ご注意ください】0
3036 円 (税込 / 送料別)

【AS ONE】分析・特殊機器|分析機器その他栄研化学 E-MR70 生培地 ポアメディア WYOα寒天 1パック(10枚入)
【アズワン AS ONE】分析・特殊機器 分離・分析ロシ 分析機器その他 ●レジオネラ属菌の選択分離用 商品の仕様 ●生培地 ●内容量:10枚 ●JANコード:4987026170800 【※ご注意ください】商品は代表の画像を使用しています。
5489 円 (税込 / 送料込)

【AS ONE】分析・特殊機器|分析機器その他ベクトン・ディッキンソン 252959 BD BBL(TM) CHROMagar(TM) カンジダII寒天培地 100枚
【アズワン AS ONE】分析・特殊機器 分離・分析ロシ 分析機器その他 ●BD BBL(TM) CHROMagar(TM) カンジタ寒天培地はC. albicans、C. tropicalis、C. krusei の分離区別のために用いられます。 ●また、他の酵母様真菌や糸状様真菌の分離においてもサブローデキストロース寒天培地または同様の培地の代わりとして用いることかできます 商品の仕様 ●生培地 ●用途:真菌、イースト、カビ用 ●入数:100枚入 ●JANコード:382902529590 【※ご注意ください】商品は代表の画像を使用しています。
30030 円 (税込 / 送料込)

栄研化学 パールコアR ハートインフュジョン寒天培地 E-MC85 1個
栄研化学 パールコアR ハートインフュジョン寒天培地 E-MC85 1個●一般細菌及び栄養要求の厳しい菌の培養及び分離用●顆粒●内容量:300g
11927 円 (税込 / 送料別)

【送料無料】アズワン サニスペック生培地 卵黄加マンニット食塩寒天 20枚入
メーカー アズワン 商品カテゴリ 実験用器具・消耗品>実験用消耗品 発送目安 1日~2日以内に発送予定(土日祝除) お支払方法 銀行振込・クレジットカード 送料 送料無料 特記事項 その他
4650 円 (税込 / 送料込)

【AS ONE】分析・特殊機器|分析機器その他極東製薬工業 2414 BCP加プレートカウント寒天培地 300g
【アズワン AS ONE】分析・特殊機器 分離・分析ロシ 分析機器その他 ●発酵乳・乳酸飲料・乳酸菌入アイスクリーム中の乳酸菌の生菌数測定に使用します。 ●乳酸菌の発育が良好で培地の深部および表面に黄変した集落を形成します。 商品の仕様 ●粉末 ●内容量:300g ●有効期限:製造日より1年 ●JANコード:4987551024142 【※ご注意ください】商品は代表の画像を使用しています。 【※ご注意ください】0
9900 円 (税込 / 送料別)

【AS ONE】分析・特殊機器|分析機器その他栄研化学 E-MR96 ポアメディア?羊血液寒天培地M70 10枚入
【アズワン AS ONE】分析・特殊機器 分離・分析ロシ 分析機器その他 ●一般細菌及び栄養要求の厳しい菌検査用 5%羊血液添加(特に肺炎球菌の集落が鮮明でA群溶血レンサ球菌のβ溶血環も鮮明) 商品の仕様 ●生培地 ●内容量:10枚 ●JANコード:4987026164809 【※ご注意ください】商品は代表の画像を使用しています。 【※ご注意ください】0
3036 円 (税込 / 送料別)

【AS ONE】分析・特殊機器|微生物検査用品島津ダイアグノスティクス 51063 アキュレート? ベアードパーカー寒天培地 1箱(10枚入)
【アズワン AS ONE】分析・特殊機器 検査用品 微生物検査用品 ●日本薬局方に準拠した培地です。 ●無菌的に調製されていますので、そのまま使用することができます。 商品の仕様 ●適用:黄色ブドウ球菌用 ●保存方法:冷暗所・4~10℃(凍結不可) ●JANコード:4987302510634 【※ご注意ください】商品は代表の画像を使用しています。 【※ご注意ください】0
2200 円 (税込 / 送料別)

【AS ONE】分析・特殊機器|分析機器その他栄研化学 E-MP01 ポアメディア?SS寒天培地 10枚入
【アズワン AS ONE】分析・特殊機器 分離・分析ロシ 分析機器その他 ●硫化水素産生性と糖分解能によるサルモネラ及びシゲラの分離用(大腸菌発育阻止作用が強く多量の糞便塗抹ができる) 商品の仕様 ●生培地 ●内容量:10枚 ●JANコード:4987026223223 【※ご注意ください】商品は代表の画像を使用しています。 【※ご注意ください】0
1683 円 (税込 / 送料別)

【AS ONE】分析・特殊機器|分析機器その他栄研化学 E-MP23 生培地 ポアメディア 血液寒天培地 10枚
【アズワン AS ONE】分析・特殊機器 分離・分析ロシ 分析機器その他 ●一般細菌及び栄養要求の厳しい菌検査用 商品の仕様 ●5%馬血液寒天培地 ●入数:10枚入 ●JANコード:4987026007052 【※ご注意ください】商品は代表の画像を使用しています。
3036 円 (税込 / 送料別)

【AS ONE】分析・特殊機器|分析機器その他島津ダイアグノスティクス 56798 ガンマ線滅菌クリーンスタンプ25「ニッスイ」SCDLP寒天(3重包装・常温) 120枚
【アズワン AS ONE】分析・特殊機器 分離・分析ロシ 分析機器その他 ●日本薬局方準拠培地 ●環境微生物検査用 ●一般生菌数測定用(不活化剤含有) 商品の仕様 ●培地表面積:25方センチメートル ●入数:120枚 ●重量:3950g ●※保存方法:2~25℃(常温) ●有効期限:製造後6ヶ月 ●JANコード:4987302567980 【※ご注意ください】商品は代表の画像を使用しています。
36300 円 (税込 / 送料込)

【AS ONE】分析・特殊機器|分析機器その他島津ダイアグノスティクス 5282 アキュディア NGKG寒天基礎培地 顆粒 300g
【アズワン AS ONE】分析・特殊機器 分離・分析ロシ 分析機器その他 ●本培地は、食品中のセレウス菌(Bacillus cereus)を選択的に分離、検出するために開発された培地である。 ●ペプトン量を低濃度とし、グリシンに置き換えることによって分離能を高めている。 ●セレウス菌はグリシンを利用して培地をアルカリ性にするため、コロニー周囲の培地が濁った赤色(卵黄反応陽性)になる。 商品の仕様 ●包装:300g ●貯蔵方法:室温に保存(要防湿) ●サイズ:W9cm×H20cm×D9cm ●JANコード:4987302052820 【※ご注意ください】商品は代表の画像を使用しています。
11385 円 (税込 / 送料込)

【AS ONE】分析・特殊機器|分析機器その他ベクトン・ディッキンソン 218263 BD Difco(TM) R2A寒天培地 500g
【アズワン AS ONE】分析・特殊機器 分離・分析ロシ 分析機器その他 ●飲料水の細菌数測定や培養に使う低栄養培地です。 商品の仕様 ●粉末培地 ●用途:従属栄養細菌用 ●質量:500g ●JANコード:382902182634 【※ご注意ください】商品は代表の画像を使用しています。
24750 円 (税込 / 送料込)

【AS ONE】分析・特殊機器|分析機器その他ベクトン・ディッキンソン 242720 BD Difco(TM) YPD寒天培地
【アズワン AS ONE】分析・特殊機器 分離・分析ロシ 分析機器その他 ●分子生物学で使用する酵母の増菌および保存用の培地です。 商品の仕様 ●粉末培地 ●用途:保存用 ●質量:500g ●JANコード:382902427209 【※ご注意ください】商品は代表の画像を使用しています。
16830 円 (税込 / 送料込)
![アズワン AS ONE 粉末培地 5404 マンニット食塩寒天 6-8814-01 [1445-0018375]](https://thumbnail.image.rakuten.co.jp/@0_mall/daishinshop/cabinet/item/1445-13/1445-0018375.jpg?_ex=128x128)
画像は代表画像です!ご購入時は商品説明等ご確認ください!アズワン AS ONE 粉末培地 5404 マンニット食塩寒天 6-8814-01 [1445-0018375]
納期目安 (メーカーに在庫がある場合)13:30までにご注文の場合約3~7日後出荷(土日祝日を除く)※表示の納期目安はあくまで目安ですのでお約束ではありません。具体的納期は都度お問い合わせください。お取り寄せ品です!ご注文後[商品欠品]及び[商品完売(廃番)]が発生する場合がございます。あらかじめご了承の上ご注文お願いいたします!またご注文の数量、お届け先によって別途送料が発生する場合がございます。その場合当店よりご連絡させていただきますのでご対応お願いいたします。商品未発送の状況でもメーカーによってはキャンセル不可となり場合もございますのでご了承の上ご注文お願いいたします。※記載の商品画像はイメージ(代表)画像ですので画像だけの情報のみでご購入はお控え頂き、必ず記載内容をご確認下さい。・本製品は研究者・事業者向け商品です。家庭用・一般用商品ではありません。・仕様・型番:5404・培地名:マンニット食塩寒天・適合:食品中のStaphylococcusspp.の検出・容量:500g・※保存方法:15~30度当社管理番号6-8814-01--検索キーワード--
11009 円 (税込 / 送料別)

【AS ONE】分析・特殊機器|分析機器その他ベクトン・ディッキンソン 218312 BD Difco(TM) ローズベンガル寒天基礎培地
【アズワン AS ONE】分析・特殊機器 分離・分析ロシ 分析機器その他 ●食物、乳製品および環境からの酵母とカビの選択的分離および菌数測定に使用します。 商品の仕様 ●粉末培地 ●用途:酵母・真菌用 ●質量:500g ●JANコード:382902183129 【※ご注意ください】商品は代表の画像を使用しています。 【※ご注意ください】0
31614 円 (税込 / 送料別)

【AS ONE】分析・特殊機器|分析機器その他●栄研化学 E-KW12 粉末培地(ボトル) ESコリマーク 寒天培地
【アズワン AS ONE】分析・特殊機器 分離・分析ロシ 分析機器その他 ●大腸菌群・大腸菌検出用 商品の仕様 ●粉末 ●内容量:300g ●JANコード:4987026159126 【※ご注意ください】商品は代表の画像を使用しています。
26510 円 (税込 / 送料込)